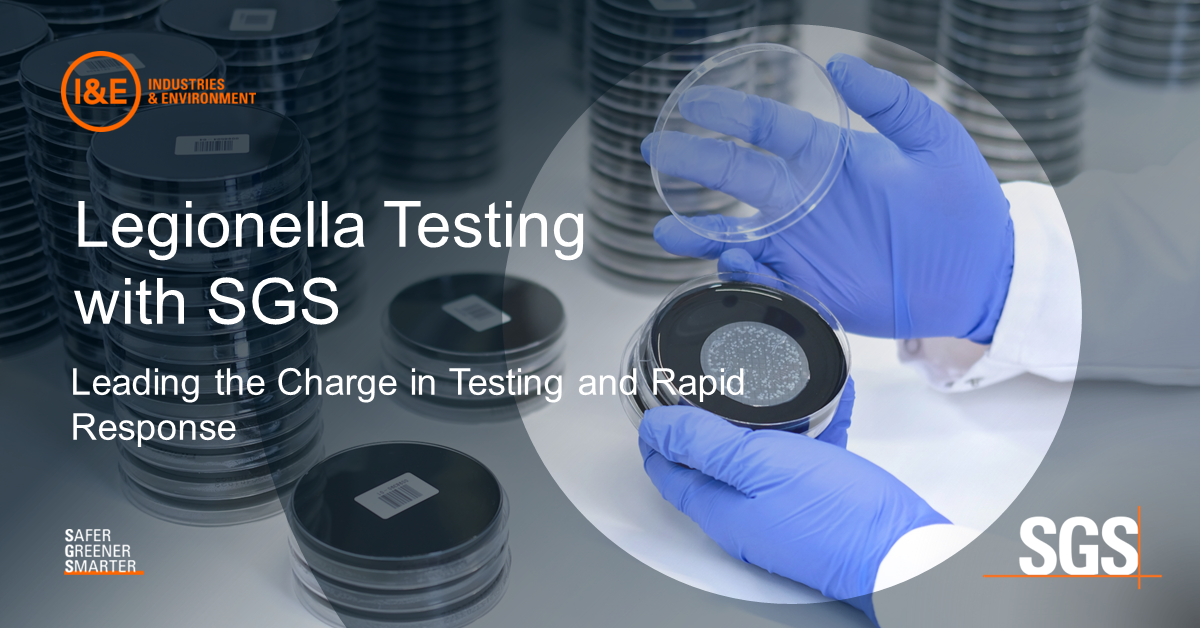

Legionella bacteria have made headlines recently, particularly with new regulations from the U.S. General Services Administration (GSA) aimed at addressing water quality and safety concerns in public buildings. However, Legionella has long been a significant public health concern, especially for facility owners and operators responsible for water systems. The bacteria can grow rapidly if the water isn’t properly managed, and when inhaled via water vapor, it can lead to serious illnesses.
Leading Legionella Testing with SGS
At SGS, we understand the critical importance of timely and accurate Legionella detection. Our laboratories have added capacity, ensuring we can handle increased testing demands. This expanded capacity allows us to continue providing the reliable and fast results our clients depend on.
Additionally, we’ve streamlined our testing process by consolidating methods to include serotyping from the very start. This optimization helps decrease incubation time, significantly improving our turnaround times. This means you receive comprehensive results faster and can take prompt corrective actions if necessary.
Why Choose SGS for Legionella Testing?
- Advanced Testing Methods: We use both culture-based and rapid PCR testing techniques, ensuring accurate detection and quantification of Legionella.
- Increased Capacity: With additional incubators in place, we’re equipped to handle high volumes of testing without sacrificing speed or accuracy.
- Proven Expertise: Our laboratories in Hayward, CA (certified since 2011) and Las Vegas, NV (certified since 2015) are CDC ELITE-certified, meaning we meet the highest standards for testing.
- Improved TAT: By including serotyping in our consolidated process, we’ve cut down incubation times, helping you get critical results even faster.
Whether you’re a building owner, facilities manager, or health and safety officer, our Legionella testing services are designed to ensure the safety and compliance of your water systems.
For more information on our testing capabilities or to speak with one of our experts, contact us today.
Contact our Client Service Representatives in a number of different ways:
- Call toll-free +1 888 398 7002
- Email [email protected]
- Visit www.sgsgalson.com/legionella/